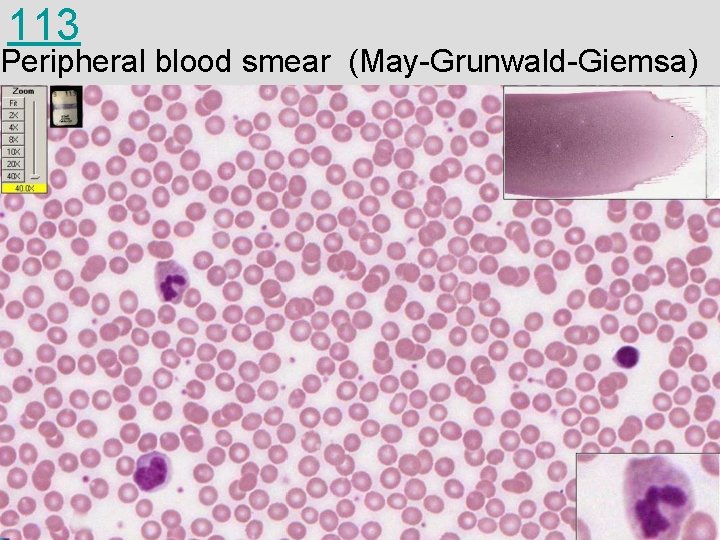
113 Peripheral blood smear (May-Grunwald-Giemsa)
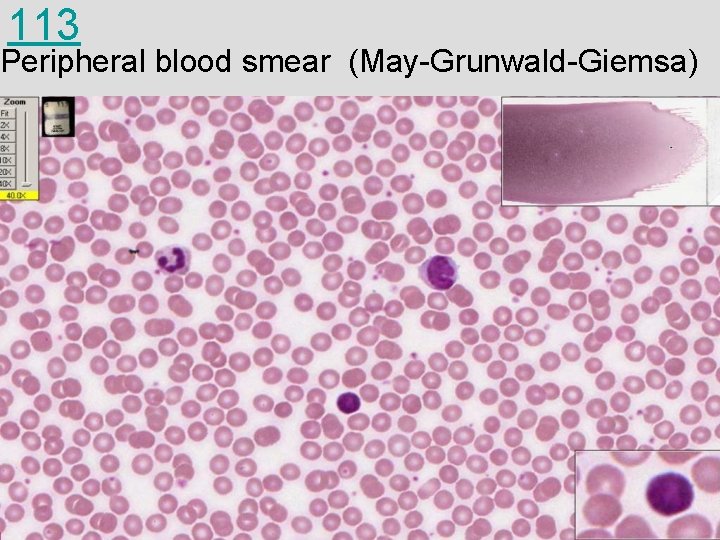
113 Peripheral blood smear (May-Grunwald-Giemsa)
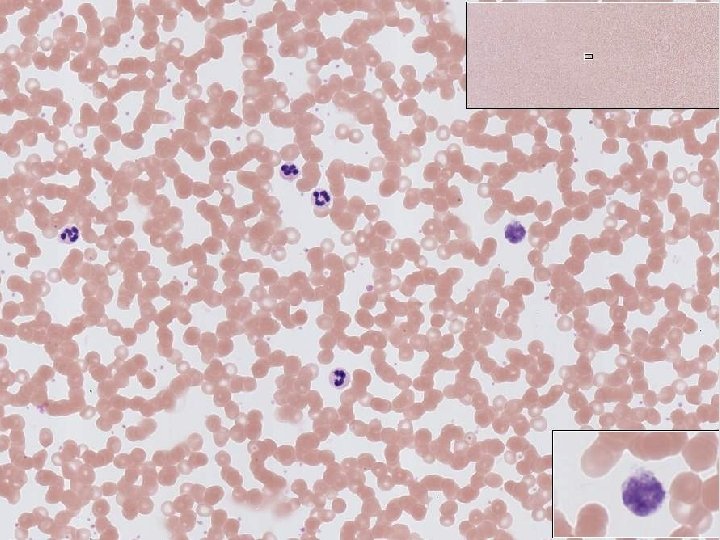
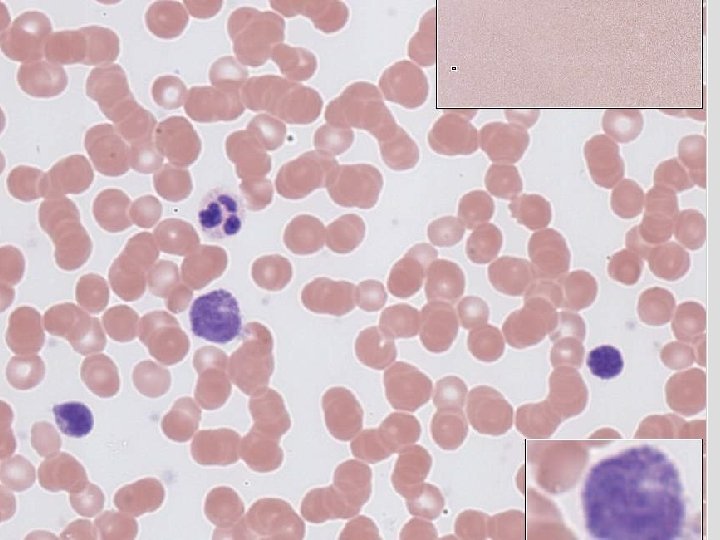
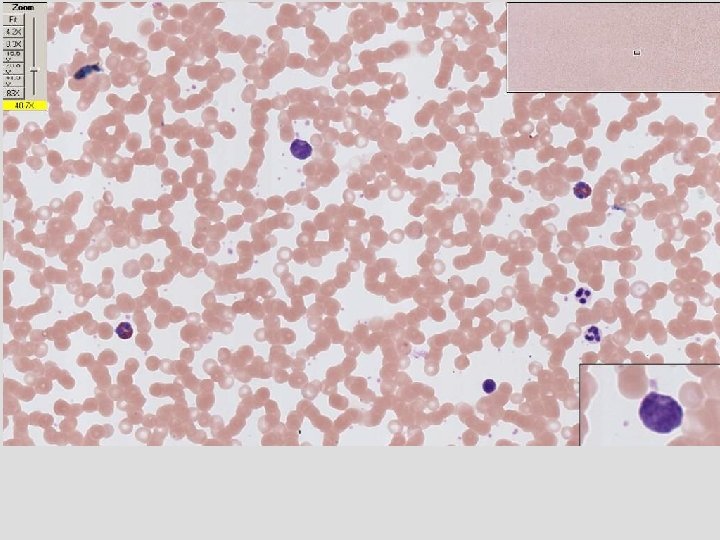
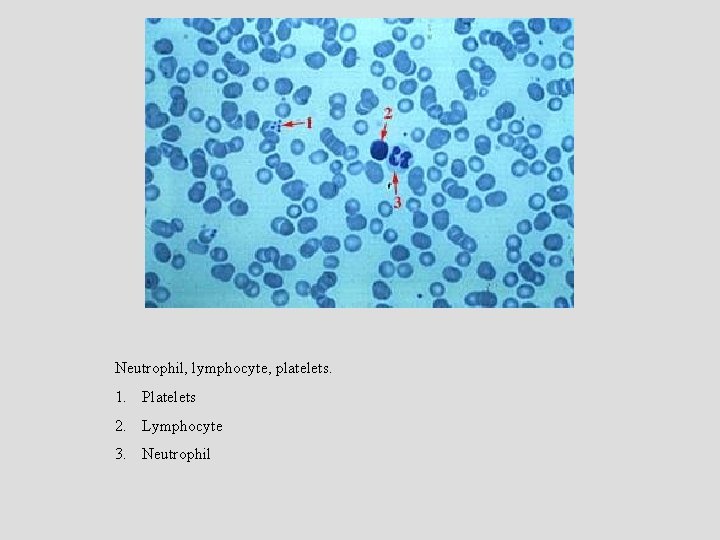
Neutrophil, lymphocyte, platelets. 1. Platelets 2. Lymphocyte 3. Neutrophil
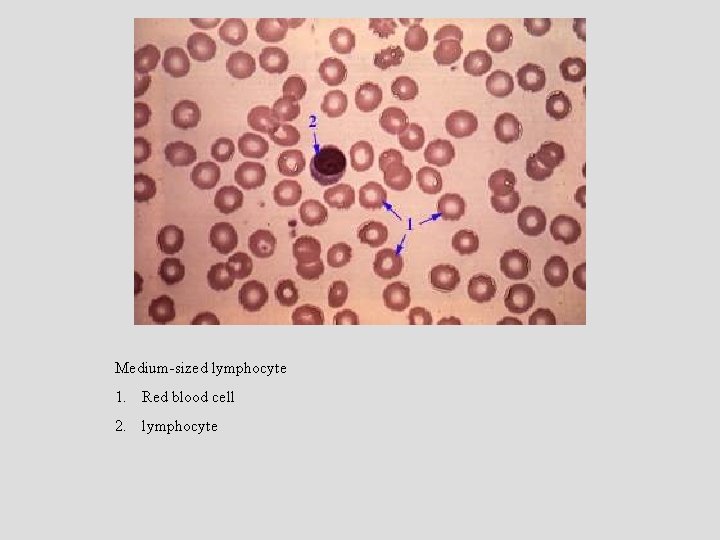
Medium-sized lymphocyte 1. Red blood cell 2. lymphocyte
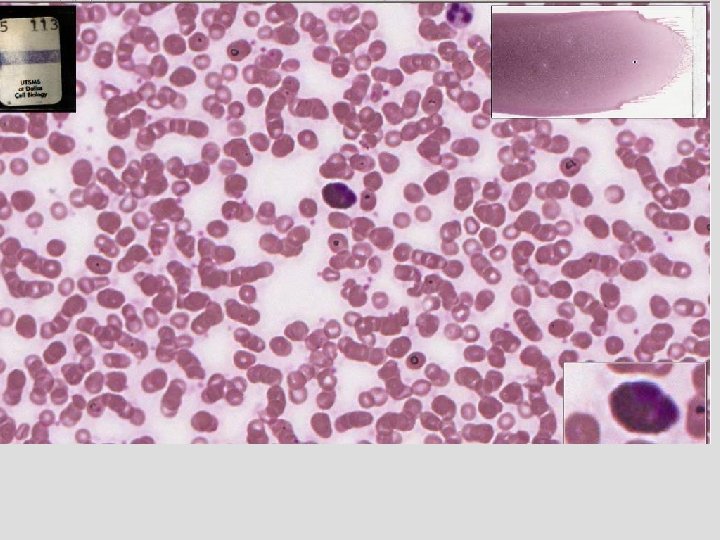

Peripheral Blood VIBS 443VIBS 602 White blood cells

Peripheral Blood VIBS 443/VIBS 602




White blood cells in blood

Slide 113

SIZE OF HUMAN BLOOD CELLS CELL/PLATELET ERYTHROCYTES LEUKOCYTES (WBC) SIZE 6. 5 -8 µm % of WBC NEUTROPHIL 60 -70% LYMPHOCYTE 12 -15 µm 6 -18 µm 25% MONOCYTE 12 -20 µm 5% EOSINOPHIL 12 -15 µm 2 BASOPHIL 12 -15 µm 0 -4% -1% PLATELETS 2 -4 µm

110 Peripheral blood smear (Leishman-Giemsa)

110 Peripheral blood smear (Leishman-Giemsa) basophil, eosinophil, and neutrophils

110 Peripheral blood smear (Leishman-Giemsa) eosinophil and neutrophil

113 Peripheral blood smear (May-Grunwald-Giemsa)
113 Peripheral blood smear (May-Grunwald-Giemsa)
113 Peripheral blood smear (May-Grunwald-Giemsa)

EM 6


Bone marrow

EM 12 a marrow

112

Bone marrow

EM 8 a marrow blood

EM 12 b

EM 8 b

EM 8 f



140 Cardiac stomach w/chronic infection

140 Cardiac stomach w/chronic infection

EM 8 b

432 Lung with bronchi – macrophage

432 Lung with bronchi

432 Lung with bronchi


EM 12 c

3 Neutrophils, 1 monocyte, 1 lymphocyte 1. Neutrophil 2. Red blood cell 3. Monocyte 4. Lymphocyte
Neutrophil, lymphocyte, platelets. 1. Platelets 2. Lymphocyte 3. Neutrophil

110 Peripheral blood smear (Leishman-Giemsa) eosinophil , basophil, and neutrophil

3 Neutrophils, 1 monocyte, 1 lymphocyte, platelet aggregates 1. Red blood cell 2. Neutrophil 3. Monocyte 4. Lymphocyte 5. Platelet
Medium-sized lymphocyte 1. Red blood cell 2. lymphocyte

2 Eosinophils, 2 neutrophils, 1 monocyte, platelet aggregates. 1. Eosinophil 2. Neutrophil 3. Platelet 4. Monocyte

1 Eosinophil, 1 neutrophil 1. Red blood cell 2. Eosinophil 3. Neutrophil

Monocyte 1. Red blood cell 2. monocyte

EM 8 f

- Slides: 55